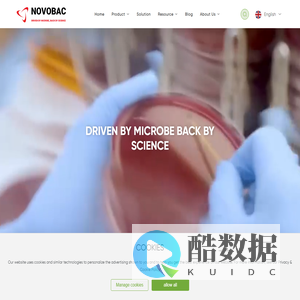
Novobac: Bio Innovations & Microbial Solutions For Agriculture

以下是关于搜索 正规高三复读学校 相关网站的结果共有 1 条,当前显示最新 30 条结果。
热门搜索
- Linux中通过Sigil创建和编辑
- 飞秒激光近视手术
- 旅游旅游规划设计
- redis缓存怎么去实现
- 园林绿化设计公司
- 全自动粘订一体机
- cDPF/sDPF全自动多工位涂覆机
- 实践API钩子拦截DLL库调用
- 中国医药文化网
- 复合金属粉末材料
- 阜阳市第一高级职业中学
- 调查Redis出现读写障碍
- 重庆蜂窝活性炭厂
- 乌鲁木齐房产网
- 自定义告警规则
- 镜子迷宫游乐设备
- 警惕QQ群信息泄露
- 山西追梦艺术教育
- 全产业链服务平台
- 截图怎么截长图
- 科技创新与品牌
- 详解MySQL的基础使用方法
- max数据库非正常退出
- 凤城市特耐捷机械
- 自贡304不锈钢水箱
- redis进入客户端命令
- 前端路由按页面ajax
- STL离心机
- 郑州百度快速排名
- пользователя
- SIS系统
- 安全乃重中之重
- 个性化定制白酒
- 轻松解决方案
- 正规高三复读学校
- Официальный
随机文章
-

1制作个性化的WordPress登陆界面的实例教程
教程大全 2026-01-08 18:59:54 -

2立即操作!-模式-Linux开启单用户模式-linux启动单用户 (立即操作数)
教程大全 2025-07-20 18:41:06 -

3夹Linux创建文件夹的简单步骤-linux如何创建文件
教程大全 2025-07-19 07:41:17 -

4安全规划咨询首购活动是如何助力企业提升安全管理水平 (安全规划咨询哪个部门)
教程大全 2025-07-18 19:50:21 -

5Ubuntu-Koala-–-操作系统-Karmic-9.10-– (ubuntu24.04)
教程大全 2025-07-16 17:19:32 -

6这是许多人在购买服务器时关心的问题-服务器打几折 (这是许多人在看书英语)
教程大全 2025-07-16 10:16:44 -

7数据库表备份-Oracle数据库表备份-为保障数据安全存储-备份至关重要!-oralce (数据库表备份sql语句)
教程大全 2025-07-16 03:22:12 -

8香港服务器极速响应-轻松应对高峰流量 (香港服务器怎么样)
教程大全 2025-07-13 03:05:00 -

9linux下ide-IDE-编辑器推荐-Linux平台下优秀的 (linux显示隐藏的文件)
教程大全 2025-07-09 00:30:31 -

10让Redis保持固定长度有效优化性能-redis设置固定长度
教程大全 2025-07-08 21:26:47 -

11搭建一个1000个用户的app服务器配置 (搭建一个100T的网盘)
VPS云服务器 2025-04-26 21:48:45 -

12网游挂机适合租用什么服务器 (网游挂机适合什么样的服务器)
VPS云服务器 2025-04-26 08:13:03
随机导航
-

1网站建设,app开发,小程序开发,网站营销,新光网络
网络应用 2026-01-08 01:34:17 -

2虎酷前端网 - 最前沿的前端技术分享
电影视频 2026-01-08 01:46:03 -

3南昌公司注册_南昌代办公司_财务代理记账-一网企业服务(江西)有限公司
商业服务 2025-05-10 16:24:33 -

4杏悦平台|杏悦娱乐-杏悦注册登录平台官网
明星娱乐 2025-05-10 16:54:35 -

5慧智博视官网 - 全栈式AI技术服务商
商业服务 2025-05-09 17:07:31 -

6顺利创富圈_中创网会员各大优质付费教程和创业项目大全
电影视频 2025-07-03 13:17:34 -

7杭州微视优信息技术有限公司
网站模板 2025-09-04 10:12:58 -

8诚信木匠-二维码定制
电影视频 2025-09-08 00:45:25 -

9河南省众昇智能门窗有限公司,河南智能门窗_南阳智能门窗_智能门窗厂家_河南众昇智能门窗_河南众昇智能门窗有限公司
企业品牌 2025-09-13 07:07:19 -

10安康通|首页
下载资源 2025-09-22 23:59:18 -
11Novobac: Bio Innovations & Microbial Solutions For Agriculture
电影视频 2025-10-05 04:30:40 -

12乐山职业技术学院-2022国家级教学成果奖申报 锻造有色金属新能源产业工匠――“阳光工坊”育人模式的创新与实践
教学课件 2025-10-08 12:23:37

